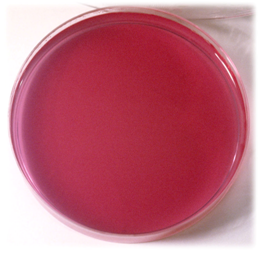

DEXTROSA TRIPTONA LEVADURA BROMOCRESOL AGAR Ensayo de fermentación para Enterobacterias (UNE 34-557:1983, ISO 21528:2004, ISO 4702:1993)
COMPOSICIÓN
Triptona 10,000 g
Extracto de Levadura 1,500 g
Glucosa 10,000 g
Cloruro de sodio 5,000 g
Púrpura de Bromocresol 0,015 g
Agar 15,000 g
(Fórmula por litro) pH final: 7,0 ± 0,1
PARA USO EXCLUSIVO EN LABORATORIO
MANTENGA EL BOTE BIEN CERRADO EN LUGAR SECO, FRESCO Y OSCURO.
AGITE EL BOTE ANTES DE USAR.
PREPARACIÓN
Disolver 41,5 gramos de medio en 1 litro de agua bidestilada. Agitar lentamente para su completa disolución. Repartir en tubos. Autoclavar a 121 ºC durante 20 minutos.
PRESENTACIÓN: MEDIO DESHIDRATADO CODIGO: DMT178
CONTROL DE CALIDAD DEL MEDIO:
Realizado en nuestro laboratorio; es prudente repetirlo en su laboratorio siempre que varíen las condiciones (más de 3 meses sin usar, tras desinfectar laboratorio, tras conservar a alta Tª, cuando adquiere aspectos extraños aunque no haya llegado la fecha de caducidad teórica de la etiqueta,…)
DESHIDRATADO: Gris azulado
PREPARADO: Púrpura-lila
CONTROL DE CRECIMIENTO 24-48 h a 37°C aproximadamente:
- E.coli MKTA 25922, Correcto, medio amarillo en 24 h
- Pseudomonas aeruginosa MKTA 9027, Correcto, medio lila
- Salmonella abony MKTN 6017, Correcto, medio amarillo en 24 h
- Staphylococcus aureus MKTA 6538P, Pobre, medio amarillo tras 48 horas
SIEMBRA E INTERPRETACIÓN
Inocular con las colonias crecidas en VRBG (DMT136 ó BCD088) e incubar a 37 ºC aproximadamente, durante 24h. Un color amarillo en la totalidad del tubo, acompañado normalmente de gas, indica una reacción positiva.
El usuario es el único responsable de la eliminación de los microorganismos según la legislación medioambiental vigente. Autoclavar antes de desechar a la basura.
Si desea más información sobre nuestros MEDIO DEXTROSA TRIPTONA LEVADURA BROMOCRESOL AGAR rellene nuestro formulario de contacto http://www.medioscultivo.com/contacto . O si lo prefiere póngase en contacto con nosotros a través de nuestro correo electrónico microkit@microkit.es o por teléfono en el nº 91-897 46 16
https://www.microkit.es/fichas/DEXTDEXTROSE-TRYPTONE-LEVADURA-BROMOCRESOL-AGAR-ENTEROBACTERIAS.pdf